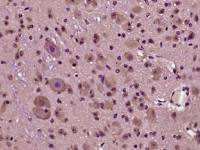
phospho-HOMER3 (Thr36)磷酸化HOMER3蛋白抗体

上海联迈生物工程有限公司品牌商
9 年
手机商铺
商家活跃:
产品热度:
- NaN
- 0
- 0
- 2
- 2
全部产品
搜索到199109条记录分类
- 细胞株(2955)
- 分子生物学(17925)
- 细胞培养基(3)
- 菌种(1360)
- ATCC(4896)
- 标准品对照品(38922)
- 重组蛋白(4882)
- 生化试剂(11592)
- 抗体(28570)
- Elisa(24479)传染病检测ELISA(1183)大鼠ELISA(1075)肝纤维化检测ELISA(739)骨代谢ELISA试剂盒(2005)活性多肽ELISA试剂盒(1874)激素ELISA试剂盒(2392)内分泌检测ELISA试剂盒(3382)特种蛋白检测ELISA(896)兔ELISA试剂盒(118)细胞调亡ELISA试剂盒(1846)细胞因子ELISA试剂盒(1009)小鼠ELISA试剂盒(1236)心肌梗塞检测ELISA(684)血栓与止血ELISA试剂盒(1207)优生优育检测ELISA(563)肿瘤标志物检测ELISA试剂盒(1251)猪ELISA试剂盒(173)自身免疫检测ELISA试剂盒(1409)其他elisa(1436)
- 代理品牌(139)
- 外泌体研究(41)
- Genwaybio (57992)
- swant(47)
- 细胞生物学试剂盒(2238)
- 其他